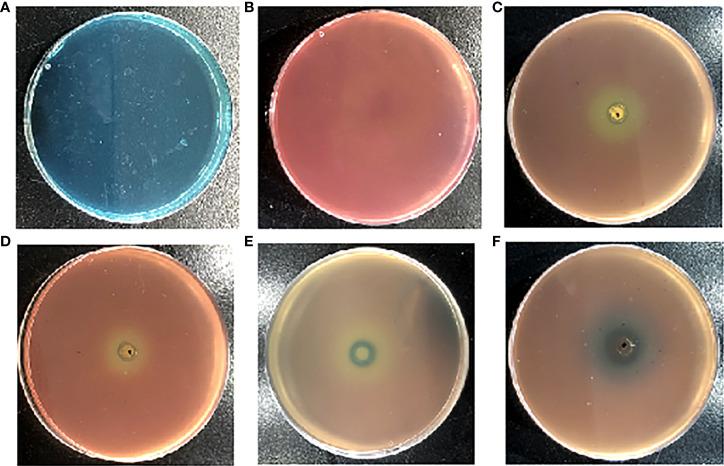
https://cdn.ncbi.nlm.nih.gov/pmc/blobs/50c0/9497652/0267b8a7a94d/fcimb-12-955952-g001.jpg
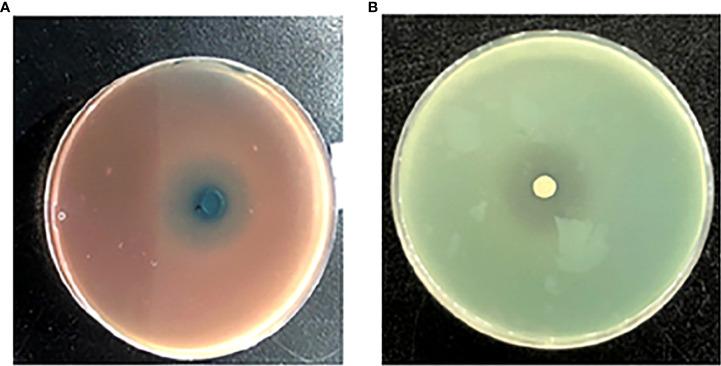
https://cdn.ncbi.nlm.nih.gov/pmc/blobs/50c0/9497652/a8e09b556ba8/fcimb-12-955952-g002.jpg

2-羟甲基-1-甲基-5-硝基咪唑,一种铁载体抑制剂,可阻断.中的群体感应。
2-Hydroxymethyl-1-methyl-5-nitroimidazole, one siderophore inhibitor, occludes quorum sensing in .
机构信息
School of Pharmaceutical Sciences, Key Laboratory of Tropical Biological Resources of Ministry of Education, Hainan University, Haikou, China.
One Health Institute, Hainan University, Haikou, China.
出版信息
Front Cell Infect Microbiol. 2022 Sep 8;12:955952. doi: 10.3389/fcimb.2022.955952. eCollection 2022.
Siderophore is necessary for the survival of microorganisms and is interregulated with quorum sensing (QS) systems. It is related to growth, proliferation, virulence, and other bacterial social activities as a virulence factor. Thus, we speculated that the QS system could be occluded by inhibiting siderophore production. 2-Hydroxymethyl-1-methyl-5-nitroimidazole (HMMN), one siderophore inhibitor of PAO1 ( PAO1), was obtained by using the Chromeazurol S (CAS) method. We found that HMMN inhibited siderophore production and influenced the biological effects of QS regulation, including biofilm formation and pyocyanin production. HMMN (150 μg/ml) inhibited the siderophore production of PAO1 by 69.37%. In addition, HMMN could inhibit pyocyanin production and biofilm formation and erase the formed biofilm of PAO1. HMMN (150 μg/ml) inhibited the biofilm formation of PAO1 by 28.24%. The erasure rate of the formed biofilm reached 17.03%. Furthermore, HMMN (150 μg/ml) inhibited PAO1 pyocyanin production by 36.06%. Meanwhile, positive-control hordenine (500.0 μg/ml) reduced the biofilm formation and pyocyanin production of PAO1 by 14.42% and 34.35%, respectively. The erasure rate of hordenine to the formed biofilm is 11.05% at 500 μg/ml. Quantitative real-time polymerase chain reaction (qRT-PCR) showed that HMMN downregulates not only siderophore-related genes but also QS-related genes, as well as hordenine. These results suggest that a siderophore inhibitor could be used as a QS inhibitor to occlude the QS system and reduce virulence.
铁载体对于微生物的生存是必需的,并且与群体感应(QS)系统相互调节。它作为一种毒力因子与生长、增殖、毒力和其他细菌社交活动有关。因此,我们推测 QS 系统可以通过抑制铁载体的产生来阻断。2-羟甲基-1-甲基-5-硝基咪唑(HMMN)是一种 PAO1(PAO1)的铁载体抑制剂,通过使用铬azurol S(CAS)法获得。我们发现 HMMN 抑制铁载体的产生,并影响 QS 调节的生物学效应,包括生物膜形成和绿脓菌素的产生。HMMN(150μg/ml)抑制 PAO1 的铁载体产生 69.37%。此外,HMMN 可以抑制绿脓菌素的产生和生物膜的形成,并擦除 PAO1 形成的生物膜。HMMN(150μg/ml)抑制 PAO1 的生物膜形成 28.24%。形成的生物膜的擦除率达到 17.03%。此外,HMMN(150μg/ml)抑制 PAO1 绿脓菌素的产生 36.06%。同时,阳性对照物霍多宁(500.0μg/ml)分别减少了 PAO1 生物膜形成和绿脓菌素产生的 14.42%和 34.35%。霍多宁在 500μg/ml 时对形成的生物膜的擦除率为 11.05%。实时定量聚合酶链反应(qRT-PCR)显示,HMMN 不仅下调铁载体相关基因,而且下调 QS 相关基因和霍多宁。这些结果表明,铁载体抑制剂可用作 QS 抑制剂来阻断 QS 系统并降低毒力。